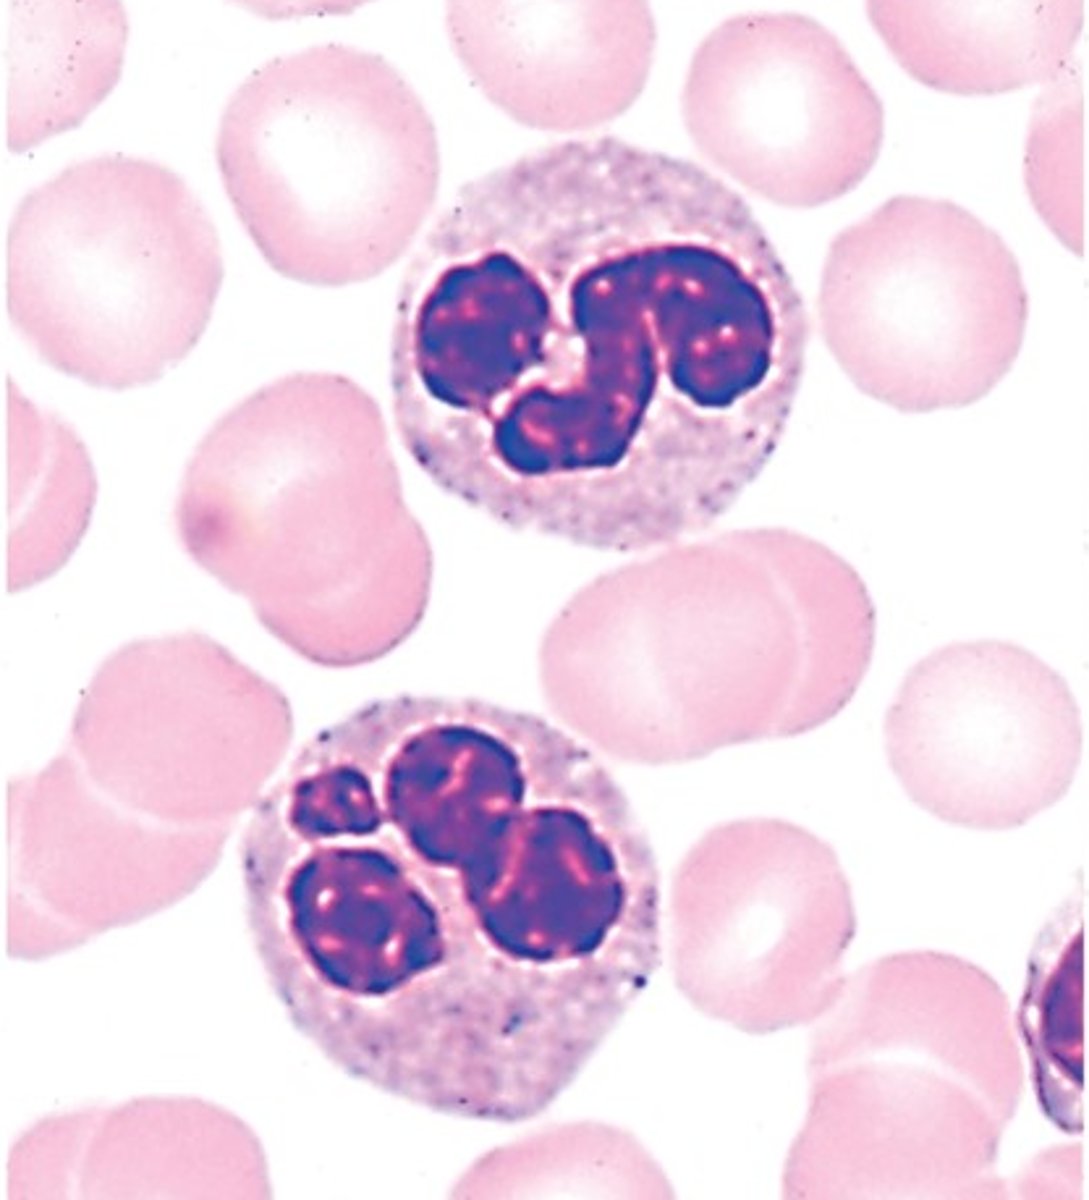
<p>Identify these leukocytes</p>
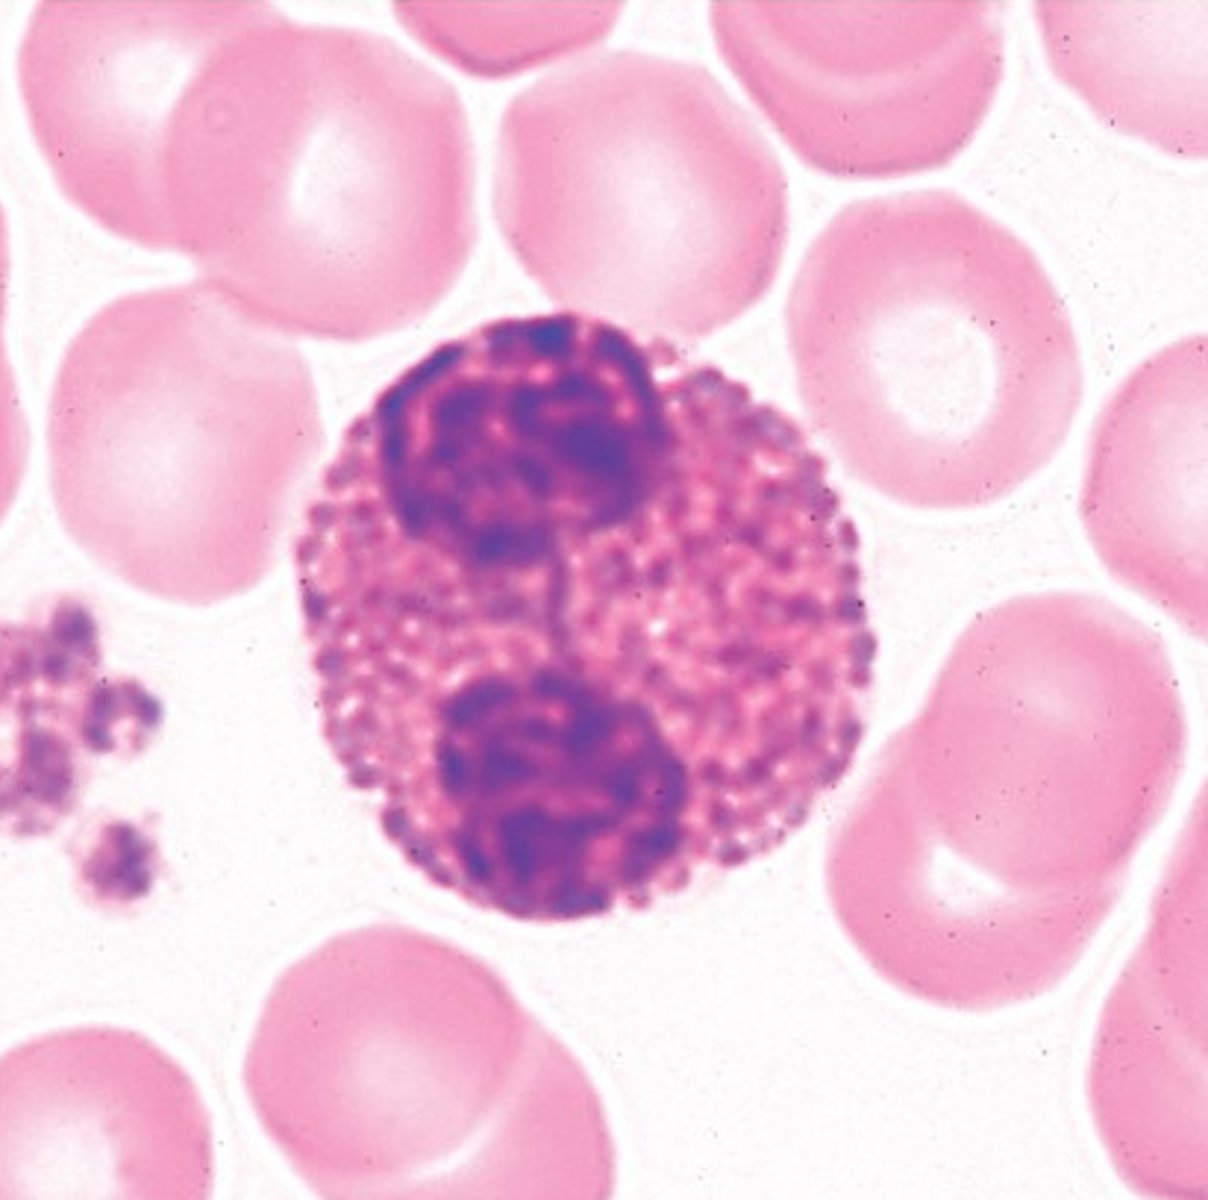
<p>Identify this leukocyte</p>
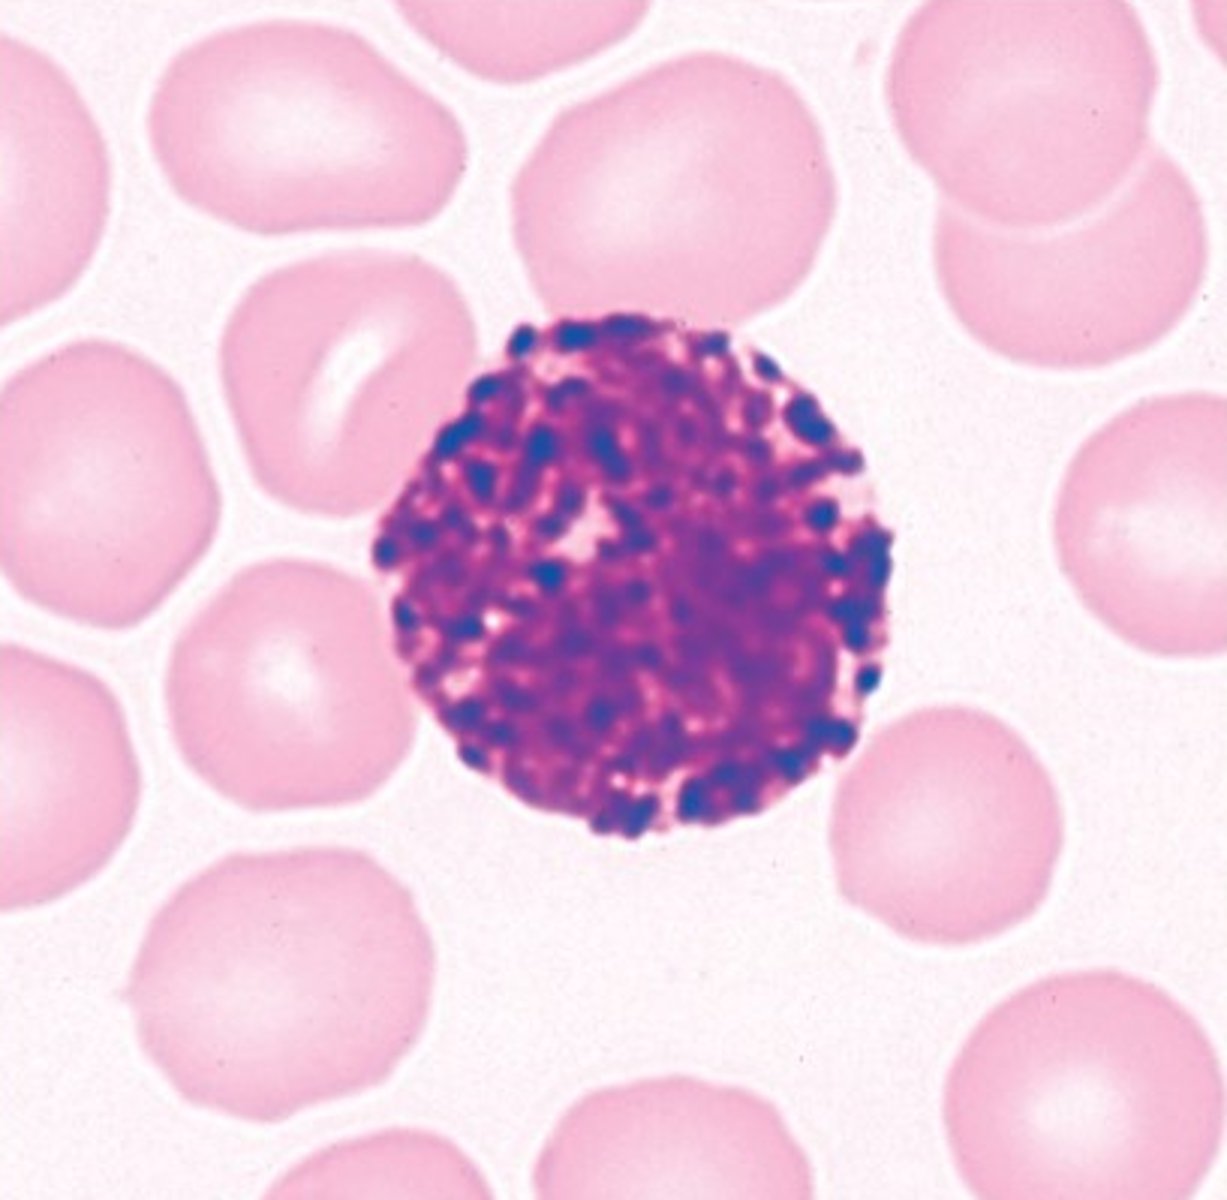
<p>Identify this leukocyte</p>
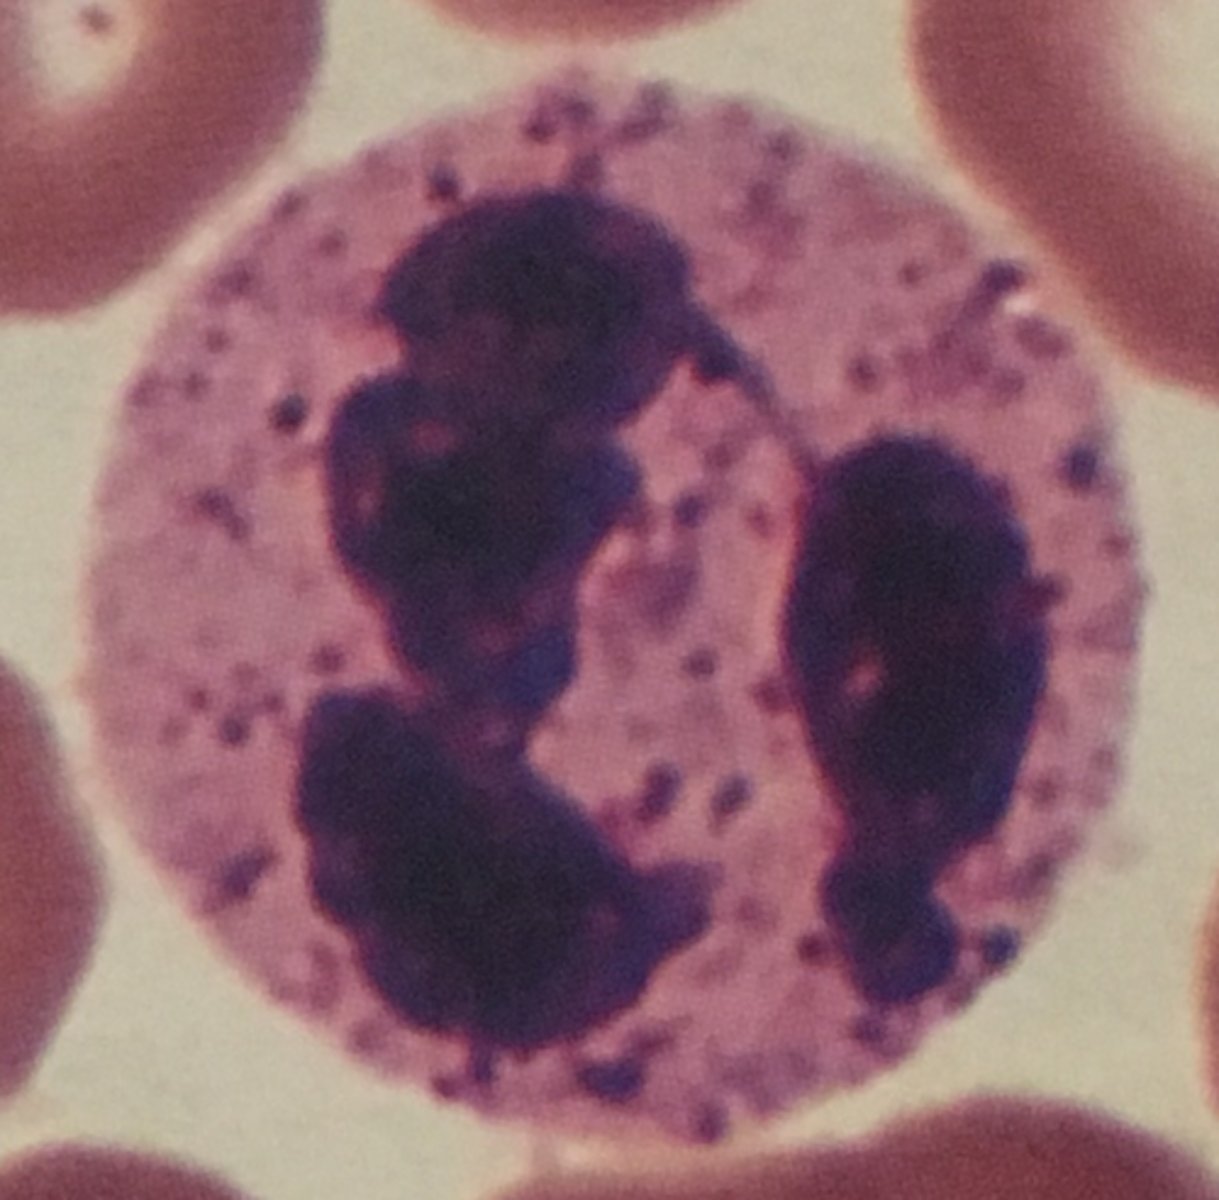
<p>Identify this leukocyte and it's functions</p>

1/30
Looks like no tags are added yet.
Name | Mastery | Learn | Test | Matching | Spaced | Call with Kai |
|---|
No analytics yet
Send a link to your students to track their progress
Neutrophil
Identify this leukocyte

Basophil
Identify this leukocyte

Eosinophil
Identify this leukocyte

Lymphocyte
identify this leukocyte

Monocyte
Identify this leukocyte

Neutrophils
Identify these leukocytes
Eosinophil
Identify this leukocyte
Basophil
Identify this leukocyte
Eosinophil - destroys parasites, helps control inflammation and allergic reactions.
Identify this leukocyte and it's functions

Basophil - Releases anti-coagulant heparin and blood vessel dilator histamine
Identify this leukocyte and it's functions

Lymphocyte - Provides immunity, produces antibodies, destroys foreign cells and cells infected by viruses
Identify this leukocyte and it's functions

Neutrophil - Phagocytizes bacteria
Identify this leukocyte and it's functions
Monocyte - Phagocytizes dead or dying cells and microorganisms
Identify this leukocyte and it's functions

50-70%
What differential leukocyte count do neutrophils make up?
30-40%
What differential leukocyte count do lymphocytes make up?
3-8%
What differential leukocyte count do monocytes make up?
2-4%
What differential leukocyte count do Eosinophils make up?
>1%
What differential leukocyte count do basophils make up?
Neutrophils, Eosinophils, and Basophils
What leukocytes are granulated?
Lymphocytes and Monocytes.
Which leukocytes are Agranulated?
Granulated (eosinophil)
Is this leukocyte granulated or agranulated?

Granulated (basophil)
Is this leukocyte granulated or Agranulated?

Agranulated (lymphocyte)
Is this leukocyte granulated or Agranulated?

Granulated (Neutrophil)
Is this leukocyte granulated or Agranulated?

Agranulated (Monocyte)
Is this leukocyte granulated or Agranulated?

Differential Leukocyte Count
It is used to determine what are the different counts of the different types of WBCs.
What does DLC stand for?
Never Let Monkeys Eat Bananas
or
No Let Monkeys Eat Bananas
This mnemonic device helps with remembering the DLC of the types of leukocytes!
What is the mnemonic device to help remember the DLC/Count of the leukocytes?
Type A
Identify this blood type
Key:
Yellow - Galactose
Blue - Fucose
Red - N-Acetylgalactosamine

Type AB
Identify this blood type
Key:
Yellow - Galactose
Blue - Fucose
Red - N-Acetylgalactosamine

Type B
Identify this blood type
Key:
Yellow - Galactose
Blue - Fucose
Red - N-Acetylgalactosamine

Type O
Identify this blood type
Key:
Yellow - Galactose
Blue - Fucose
Red - N-Acetylgalactosamine
